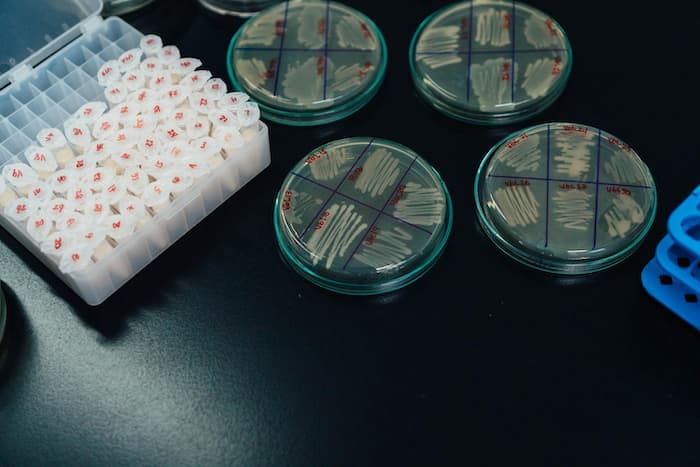
m/بار میکروبی

بار میکروبی؛سطوح بار میکروبی هوای داخلی در بیمارستان ها برای سلامت بیماران و کارکنان مراقبت های بهداشتی بسیار حیاتی است و باید به طور منظم نظارت و در سطح قابل قبولی حفظ شود.
آلودگی هوای میکروبیولوژیکی در سالنهای عمل (OTs) و اتاقهای زایمان (LRs) یک عامل خطر اصلی برای عفونت محل جراحی است. نظارت معمول در مناطق آسیبپذیر مانند OTs و LRs باید همیشه به عنوان بخشی از کنترل عفونت برای ارزیابی آلودگی توسط میکروارگانیسمها و نظارت بر وجود عوامل بیمارستانی انجام شود.
یا دست های کارکنان مراقبت های بهداشتی (HCWs) به عنوان مسیر اصلی برای انتقال عفونت بیمارستانی عمل می کند. اگرچه شستن دست ها برای کاهش انتقال عفونت متقاطع شناخته شده است، تأثیر حلقه ها بر اثر شستن دست ها و حمل باکتری بر روی دست ها به خوبی ثابت نشده است.
برای دریافت خدمات و کسب اطلاعات بیشتر با ما تماس بگیرید
(HAI) که به عنوان عفونت بیمارستانی نیز شناخته می شود، عفونتی است که در یک بیمارستان یا سایر مراکز مراقبت های بهداشتی به دست می آید.
چنین عفونتی می تواند توسط بیماران مستعد در بیمارستان، آسایشگاه، مرکز توانبخشی، کلینیک سرپایی یا سایر محیط های بالینی موجب آلودگی شود.
کارکنان مراقبت های بهداشتی علاوه بر تجهیزات آلوده، ملحفه یا قطرات هوا می توانند عفونت را گسترش دهند.
عفونت میتواند از محیط بیرون، بیمار آلوده دیگر، کارکنانی که ممکن است آلوده باشند، منشأ میگیرد یا در برخی موارد نمی توان منبع عفونت را تعیین کرد.
در برخی موارد، میکروارگانیسم از میکروبیوتای پوست خود بیمار سرچشمه میگیرد و پس از جراحی یا سایر روشهایی که سد محافظ پوست را به خطر میاندازد، موجب آلودگی میشود.
اگرچه ممکن است بیمار عفونت را از پوست خود گرفته باشد، اما عفونت هنوز بیمارستانی در نظر گرفته می شود زیرا در محیط مراقبت های بهداشتی ایجاد می شود.
منبع اصلی میکروارگانیسم ها انسان است زیرا از طریق فعالیت های انسانی مانند سرفه، عطسه، خندیدن و حتی صحبت کردن ترشح می شود.
عفونتهای بیمارستانی یکی از جدی ترین عوارض در محیط های بیمارستانی است که بر بیماران بستری در بخش مراقبت های ویژه، افراد مبتلا به ضعف سیستم ایمنی، کارکنان بیمارستان و افرادی که به طور مکرر با مراکز مراقبتهای بهداشتی برخورد میکنند، تأثیر میگذارد.
عفونتهای بیمارستانی در بیماران ICU منجر به استفاده از آنتی بیوتیکهای وسیع و ظهور میکروارگانیسم های مقاوم به آنتی بیوتیک میشود که در نهایت منجر به عوارض، مرگ ومیر بالا و هزینه درمان عفونت و اقامت طولانی مدت در بیمارستان میشود.
شایع ترین باکتری های عامل عفونت بیمارستانی مانند استافیلوکوکوس اورئوس و سودوموناس گونه ها ی آن ها هستند.
گاز، ذرات غبار، بخار آب و هوا حاوی میکروارگانیسم ها هستند. سلول های رویشی و اسپور باکتری ها، قارچ ها، جلبک ها، ویروس ها و کیست های تک یاخته ای وجود دارد.
از آنجایی که هوا اغلب در معرض نور خورشید است، دمای بالاتر و رطوبت کمتری دارد. هوا به عنوان وسیله انتقال یا پخش برای میکروارگانیسم ها عمل می کند. بنابراین در مقایسه با خاک و آب به تعداد نسبتاً کمی در هوا وجود دارند.
شایع ترین جنس باکتری هایی که در هوای داخل خانه یافت می شوند، استافیلوکوک ها، باسیل ها و کلستریدیوم هستند.
امروزه مشخص شده است که MRSA (استافیلوکوک اورئوس مقاوم به متی سیلین) و باکتری های گرم منفی مقاوم به جنتامایسین جدی هستند.
افراد 80 تا 90 درصد از زمان خود را با تنفس 14 متر مکعب هوا در روز در محیط های داخلی می گذرانند.
علاوه بر این، عوامل محیطی و فیزیکی به ترتیب شامل دما، رطوبت، نرخ تبادل هوا، حرکت هوا و سازههای ساختمان، مکان، طراحی ضعیف، سیستم تهویه و همچنین طراحی مجدد داخلی هستند که رشد و تکثیر میکروارگانیسمها را در فضای داخلی افزایش میدهند.
مقالات بیشتر:
بررسی قابلیت رشد و مهار میکروب ها (GPT)
بررسی خاصیت ضد میکروبی انواع ضد عفونی کننده های پزشکی
این گزارش اطلاعاتی در مورد کیفیت هوای داخل ساختمان و خطرات احتمالی مرتبط با آن در بیمارستان ها ارائه می دهد. گسترش و تداوم جوامع میکروبی در محیط های بیمارستانی از اهمیت زیادی برای سلامت عمومی برخوردار است.
بیمارستانها با خطر عفونی بالا مشخص میشوند، اولاً علت به خطر افتادن شرایط ایمونولوژیک بیماران است که آن ها را در برابر عفونتهای فرصت طلب باکتریایی، ویروسی، انگلی و قارچی آسیب پذیر میکند.
شواهد نشان می دهد که عوامل میکروبی از طریق هوا، سطوح، آئروسل و دست پخش می شوند. اگر سطوح ممکن است به عنوان یک مخزن برای برخی عوامل بیماری زا عمل کنند، دست ها یک مسیر مهم انتقال هستند.
میکروارگانیسمهای موجود در هوا و ذرات معلق در آب مورد توجه قرار گرفته و حضور آن ها در محیطهای بیمارستانی بررسی میشود.
اصطلاح محیط بیمارستانی شامل ساختمان های بیمارستان و محیط های مراقبت های بهداشتی با تمام اجزای داخلی است که آن ها را متمایز می کند:
- افراد شاغل (افراد بیمار، بازدیدکنندگان و کارکنان بیمارستان)،
- هوای داخل ساختمان،
- سطوح،
- تجهیزات پزشکی،
- داروها،
- تجهیزات پزشکی،
- مواد غذایی و ضایعات
همه این اجزا ممکن است به طور بالقوه از بقا و رشد عوامل بیولوژیکی حمایت کنند. چگونگی تداوم جوامع میکروبی و تغییر در محیطهای داخلی، نگرانی زیادی برای سلامت عمومی دارد.
در واقع، مطالعات اخیر نشان داده است که وقتی انسان فضایی را اشغال می کند، انسان در آنجا میکروبیوتای آن فضا را تغییر می دهد .
در بیمارستانها، افراد میتوانند در معرض آئروسل های زیستی، ذرات با منشأ بیولوژیکی معلق در هوا قرار بگیرند و احتمال ابتلا به یک پاتوژن میکروبی زیاد است.
قرار گرفتن انسان در معرض عوامل بیماری زا ممکن است با طیف وسیعی از مسائل عمده بهداشت عمومی مانند بیماری های عفونی، اثرات سمی حاد و آلرژی همراه باشد.
محیط های بیمارستانی با خطر عفونی بالا شناخته میشوند، اولاً علت شرایط ایمنی به خطر افتاده بیماران است که آن ها را در برابر عفونت های فرصت طلب باکتریایی، ویروسی، انگلی و قارچی آسیب پذیر میکند .
انتقال بالقوه مواد بیولوژیکی در طی عملیات جراحی و درمان های پزشکی افراد آلوده باعث می شود که محیط های بیمارستانی به شدت به گونه ای طراحی شوند که به راحتی با انتشار پاتوژن ها در بین بیماران آلوده شوند.
علاوه بر این، در دهههای اخیر، اگر استفاده از آنتی بیوتیکها ابزاری عالی برای پیشگیری از عفونتهای بیمارستانی بوده است، استفاده گسترده از این داروها به ناچار منجر به بروز وقایع مقاومت آنتی بیوتیکی شده است.
ساختمان های بیمارستانی ممکن است به عنوان محیط های پویا تحت تأثیر عوامل متعددی در نظر گرفته شوند که به طور فعال در تعریف خطر عفونی برای بیماران نقش دارند.
جنبه هایی که باید در نظر گرفته شوند با تعداد سرنشینان (علاوه بر بیماران، کارکنان پزشکی و بازدیدکنندگان)، وضعیت مؤثر سلامتی، عادات بهداشتی و فعالیت آن ها که در هر زمانی در بیمارستان رخ می دهد نشان داده می شود.
شرایط بهداشتی سایت ها و اتاق ها، مصالح ساختمانی و تجهیزات، اثاثیه نیز بر ترکیب جامعه میکروبی تأثیر می گذارد.
بهعلاوه، دستگاههای فن آوری مانند سیستمهای هیدرولیک، گرمایش و تهویه مطبوع ممکن است منبع بالقوه باکتریها، قارچها (کپکها)، ویروسها و سایر ارگانیسم ها باشند، اگر به اندازه کافی طراحی نشده و تحت یک تعمیر و نگهداری پیشگیرانه برنامه ریزیشده قرار نگیرند.
شرایط ریزاقلیمی و رویدادهای تصادفی می تواند از رشد میکروبی و قارچی (نفوذ آب و تراکم) حمایت کند و باعث ایجاد شرایط مضر داخل ساختمان شود. بار میکروبی فضای باز و ویژگی های آب و هوایی فصلی نیز بر کیفیت میکروبیولوژیکی هوای داخل بیمارستان تأثیر می گذارد.

منابع عفونت های اکتسابی بیمارستانی و راه های انتقال
عفونت های بیمارستانی به عنوان عامل مهم ناتوانی و مرگ و میر در بیماران دچار نقص ایمنی و بیماری های زمینه ای شدید در حال ظهور هستند.
هر سال 2 میلیون بیمار از عفونت های بیمارستانی رنج می برند و نزدیک به 100000 نفر از آن ها می میرند .
داده های سازمان بهداشت جهانی نشان می دهد که در 100 بیمار بستری شده در بیمارستان، انتظار می رود 7 تا 10 نفر حداقل به یک عفونت مرتبط با مراقبت های بهداشتی مبتلا شوند .
با این حال، بار واقعی به دلیل دشواری جمع آوری داده های قابل اعتماد ناشناخته است. در واقع تشخیص عفونت های بیمارستانی پیچیده و بر اساس معیارهای متعدد است و نه بر اساس یک آزمایش آزمایشگاهی.
در مراکز بهداشتی و درمانی، منابع اصلی عفونت، بیماران و کارکنان مراقبت های بهداشتی هستند، اگرچه محیط نیز نقش مهمی ایفا می کند.
در واقع، محیط ممکن است به عنوان یک مخزن برای میکروارگانیسم های عفونی بالقوه عمل کند و ممکن است به انتشار آنها کمک کند. در نتیجه، باکتری ها در سطوح بی جان، تجهیزات و هوای داخل خانه نیز رایج هستند.
بیماران مبتلا میکروارگانیسمها را از طریق ترشح قطرات خلط آور، مایعات ناشی از زخمهای عفونی، مدفوع، ادرار، خون، سایر مایعات بدن و همچنین از طریق لباسها و پتوها در بیمارستان پخش میکنند. علاوه بر میکروارگانیسمهای بیماریزا، فلور درونزای بیماران میتواند منبع ثابتی از میکروبها باشد.
انتشار میکروبی بیشتر از طریق قطرات بزرگ، تماس مستقیم با مواد عفونی یا از طریق تماس با اجسام بی جان آلوده به مواد عفونی رخ می دهد.
تماس مستقیم بین بیماران نادر است. دست پرسنل بالینی می تواند میکروارگانیسم های عفونی را گسترش دهد و شایع ترین عامل عفونت های بیمارستانی باشد.
بنابراین، بهداشت دست به عنوان اقدام اولیه برای کاهش عفونت شناخته می شود.
حتی افراد سالم و کارکنان ممکن است به عنوان ناقلین در صورت آلوده شدن یا استعمار عمل کنند.
پاتوژن هایی مانند استافیلوکوکوس اورئوس، استافیلوکوک پیوژنز، نایسریا مننژیتیدیس، کورینه باکتریوم دیفتری، ویروس هپاتیت B، سیتومگالوویروس می توانند توسط ناقلین بدون علامت منتقل شوند.
پاتوژن ها و پاتوژن های فرصت طلب ممکن است در سیستم های توزیع آب و در آئروسل آزاد شده توسط سیستم های خنک کننده آب (مانند Legionella sp.، Mycobacterium sp.) وجود داشته باشند.
آلودگی میکروبی همچنین می تواند در داروها در حین توزیع بین بیماران و در غذاهای فرآوری شده نادرست رخ دهد. علاوه بر این، زباله های بیمارستانی که به درستی و به سرعت حذف نمی شوند، می توانند به منبع آلودگی مضر تبدیل شوند.
میکروارگانیسم هایی که می توانند از طریق تماس پخش شوند شامل مواردی هستند که با زرد زخم، آبسه، بیماری های اسهالی، گال و ارگانیسم های مقاوم به آنتی بیوتیک (استافیلوکوکوس اورئوس مقاوم به متی سیلین و انتروکوک های مقاوم به وانکومایسین) مرتبط هستند. انتقال ناقلین به مناطقی محدود می شود که حشرات، بندپایان و انگل ها در آن ها گسترده هستند.
آب و محلول های آبی مورد استفاده در مراکز بهداشتی و درمانی اغلب با عفونت های بیمارستانی مرتبط هستند. علیرغم تصفیه آب و کلرزنی، آب ورودی به سیستم های توزیع بیمارستانی ممکن است حاوی غلظت های پایینی از میکروارگانیسم های مختلف باشد اتوکتون آمیب، مانند Pseudomonas sp.، Legionella sp.، mycobacteria nontuberculous، Acinetobacter sp.، Aeromonas sp.، Sphingomonas sp.، Enterobacter sp.، Aspergillus sp. که ممکن است باعث عفونت های فرصت طلب مهم بالینی شوند.
این میکروارگانیسمها که در ماتریکسی از پلیمرهای آلی خارج سلولی ترکیب شده با ذرات غیرآلی جاسازی شدهاند، می توانند بیوفیلمها را در سیستم لوله کشی تأسیسات بهداشتی، مخازن آب گرم، برج های خنک کننده تهویه مطبوع، سینکها، سر دوشها و هواکشهای شیر القا کنند.
علاوه بر داشتن ویژگیهای هر گروه، بیوفیلم مانعی ایجاد میکند، بنابراین از پاکسازی کامل محیط جلوگیری میکند و از حذف کامل میکروارگانیسمها و در نتیجه حضور بازماندگانی که در عین حال میتوانند در برابر بیوسیدها مقاومت ایجاد کنند، جلوگیری میکند. انتقال این مقاومت، چه ژنتیکی، حتی در میکروارگانیسم های گونه های دیگر.
برخی از باکتریهای بیوفیلم ساز مانند لژیونلا، کلبسیلا، پانتوئا آگلومرانس، اسینتوباکتر بومانی و انتروباکتر کلوآکا میتوانند باعث عفونتهای بیمارستانی شوند و نسبت به حالت پلانکتونیک خود در برابر ضدعفونیکنندهها و آنتیبیوتیکها مقاوم تر هستند.
بیوفیلم می تواند به عنوان یک مخزن میکروبی عمل کند که به طور مداوم میکروب های زنده را در جریان آب آزاد می کند. سپس آب لوله کشی ممکن است سطوح، وسایل و ابزار پزشکی و همچنین آندوسکوپ ها، ماشین های دیالیز، نبولایزرها، مرطوب کننده ها و هواکش ها را آلوده کند.
راه های انتقال پاتوژن های موجود در آب شامل تماس مستقیم، بلع آب، تماس غیر مستقیم و استنشاق بیوآئروسل ها می باشد. سودوموناس آئروژینوزا و لژیونلا پنوموفیلا مهم ترین پاتوژن های موجود در آب در مراکز بهداشتی درمانی هستند.
- aeruginosa یک میکروارگانیسم رایج محیطی است. این اغلب با عفونت های بیمارستانی، به ویژه در میان بیماران دارای تهویه مکانیکی یا نقص ایمنی در بخش های مراقبت های ویژه همراه است.
مخزن اصلی P. aeruginosa فلور درونزای بیماران در نظر گرفته میشود و انتقال افقی در بین بیماران مدتهاست که شایع ترین منبع عفونت P. aeruginosa در نظر گرفته میشود.
مطالعات دیگر نشان داده است که از بیمار به بیمار از طریق دست کارکنان مراقبت های بهداشتی یا از طریق فومیت ها پخش می شود.
با این حال، در طول سالهای گذشته، استفاده از روشهای تایپ مولکولی، شناسایی آب لوله کشی تامین شده توسط بخشهای مراقبتهای ویژه را بهعنوان منبع قابل توجهی از جدایههای P. aeruginosa برونزا ممکن کرد.
بررسی مطالعات آینده نگر نشان داد که بین 14.2 تا 50 درصد از موارد عفونت/کلونیزاسیون در بیماران به دلیل ژنوتیپ های موجود در آب بخش مراقبت های ویژه است.
- pneumophila به عنوان اولین پاتوژن موجود در آب شناخته شده است که از طریق استنشاق منتقل می شود.
انتقال آن برای بیماران مبتلا به بیماری مزمن ریوی و کسانی که تحت بیهوشی عمومی قرار می گیرند، خطر قابل توجهی را نشان می دهد.
در بیمارستانها، وضعیت سرکوبکننده سیستم ایمنی بیماران و سایر عوامل خطر نه تنها باعث افزایش خطر ابتلا به عفونت میشود، بلکه باعث بروز بیشتر مرگومیر نسبت به سایر محیطها میشود.
از 5 تا 20 درصد لژیونلوزهای اعلام شده منشأ مرتبط با مراقبت های بهداشتی دارند.
در محیطهای مراقبتهای بهداشتی، نه تنها مرطوبکنندهها، دستگاههای تنفسی و برجهای خنک کننده، بلکه دوشها و شیرهای آب نیز مخازن خاص لژیونلا هستند .
مایکوباکتریهای غیر سلی (NTM)، حتی مایکوباکتریهای محیطی نامیده میشوند، همچنین مسئول عفونتهای مرتبط با مراقبتهای بهداشتی از طریق راه تنفس و تماس مستقیم هستند.
ساختار دیواره سلولی آن ها به ویژه غنی از لیپیدهای با زنجیره بلند و توانایی تشکیل بیوفیلم به مقاومت آنها در برابر مواد شیمیایی کمک می کند و از ماندگاری آنها حمایت می کند.
در واقع، NTM اغلب در سیستمهای توزیع آب یافت میشود و میتوان آن را از طریق دوشها و شیرهای آب آئروسل کرد. یک بررسی میکروبیولوژیکی انجام شده توسط نویسندگان، وجود NTM را در لوله کشی آب یک بیمارستان پس از وقوع برخی موارد مایکوباکتریوز آتیپیک در بخش های بیمارستان تایید کرد.
از آنجایی که خطر ناشی از وجود NTM در آب با روشهای ضدعفونی کلاسیک آب قابل کنترل نیست، فیلترها در محل استفاده به عنوان بهترین گزینه برای به حداقل رساندن خطر توصیه میشوند.

علاوه بر این، سیستم های توزیع آب ممکن است مخازن داخلی بالقوه قالب هایی مانند Aspergillus sp.، zygomycetes، Fusarium sp. و سایر قارچ ها دوش و شیر آب می تواند منابع خطر برای آئروسل شدن هاگ قارچ باشد (Anaissie et al. 2003). کپک ها در طبیعت همه جا وجود دارند و تقریباً در هر مکانی در داخل یا خارج از خانه رشد می کنند. افراد می توانند از طریق تماس با پوست، استنشاق یا بلع در معرض کپک قرار گیرند. به دلیل فراگیر شدن کپک در محیط، سطحی از قرار گرفتن در معرض اجتناب ناپذیر است. معمولاً فرض میشود که استنشاق مهمترین مکانیسم قرار گرفتن در معرض قارچهای زنده (زنده) یا غیر زنده (مرده)، قطعات یا اجزای قارچی است. اکثر اسپورهای قارچ دارای قطرهای آیرودینامیکی 2-10 میکرومتر هستند که در محدوده اندازه ای هستند که اجازه می دهد ذرات در دستگاه تنفسی فوقانی و تحتانی رسوب کنند. قرار گرفتن در معرض اسپور قارچی استنشاقی مستلزم آن است که اسپور ابتدا در محل رشد آئروسل شود. به طور کلی، افراد با نقص دفاعی میزبان از شدیدترین انواع عفونت های قارچی رنج می برند.
گسترش میکروارگانیسم های موجود در هوا
میکروارگانیسم های بیمارستانی در هوا برای افراد سالم ظاهرا بی ضرر هستند. با این وجود، آنها می توانند اثرات نامطلوب سلامتی در افراد دارای نقص ایمنی داشته باشند.
خود بیمارستان و سیستمهای تکنولوژیکی آن میتوانند منابع مضری را برای کیفیت هوای داخل خانه ارائه دهند. سیستم های تهویه مطبوع و گیاهان هوازی می توانند در طول زمان آلوده شوند و آلاینده های مختلفی مانند گرد و غبار و موجودات بیولوژیکی را به دام بیندازند.
رطوبت حاصل از آن ها می تواند در داخل مجاری متراکم شود و از رشد میکروبی حمایت کند.
بنابراین در بیمارستان ها، هواگیری و تهویه ویژه برای جلوگیری از انتقال هوا مورد نیاز است .
تهویه ناکافی در انتقال باکتری ها از طریق هوا نقش دارد .
بیوآئروسل از طریق پوشش هوا در طیف وسیعی از اندازه پخش می شود. قطرات بزرگتر از 5 میکرومتر هستند و منشا آنها عمدتاً سرفه، عطسه یا صحبت کردن است. در بیمارستان ها، عملکردهای پزشکی خاص مانند ساکشن و برونکوسکوپی، ذرات با این اندازه را پخش می کنند. در بین عفونت های منتقله از قطرات، آبله، سرخک، آبله مرغان، سل، بیماری مننگوکوک، ذات الریه ناشی از مایکوپلاسما، سارس و آنفولانزا بیشترین ارتباط را دارند.
ذرات کوچک باقیمانده از قطرات تبخیر شده (5 میکرومتر یا کوچکتر در اندازه) و ذرات گرد و غبار حاوی عوامل عفونی ممکن است برای مدت طولانی در هوا معلق بمانند. به این ترتیب، میکروارگانیسم ها می توانند به طور گسترده ای توسط جریان هوا در فاصله طولانی تری از منبع پخش شوند. انتقال عفونت ها از طریق هوا فقط مربوط به میکروارگانیسم هایی است که به تعداد زیاد با دوز عفونی کم در هوا پخش می شوند. عوامل کلیدی موثر بر سطح بار میکروبی موجود در هوا، تراکم و رطوبت سرنشین بسته به مکان خاص در بیمارستان است.
در بیمارستان، قالبهای کیفیت هوای داخلی اغلب به ویژه در طول فعالیتهای ساخت و ساز/تعمیر بازیابی میشوند. اسپورهای قارچ دارای سرعت ته نشینی پایینی هستند که برای مدت طولانی در هوا باقی می مانند.
بیماران ضعیف بستری شده در بیمارستان بیشتر مستعد عفونتهای ناشی از قارچهای مزوفیل طبیعی هستند و در دهههای گذشته، میزان مرگ و میر بالایی در بیماران پیوندی و بیماران لوسمی گزارش شده است.
اگرچه توصیههایی وجود دارد، به دلیل کمبود در رابطه بین دادههای بررسی میکروبیولوژیکی و پیامدهای اپیدمیولوژیک آنها، یک استاندارد مرجع برای پارامترهای میکروبیولوژیکی کیفیت هوای داخل ساختمان در مراکز بهداشتی وجود ندارد.
سطوح به عنوان منابع بالقوه عفونت
در اتاقهای بیمارستان، سطوح اغلب با پاتوژنهایی آلوده میشوند که میتوانند برای مدت طولانی روی سطوح اتاق (تخت، ملحفه، کف، دیوار و مبلمان) و تجهیزات پزشکی زنده بمانند
عوامل بیولوژیکی ممکن است توسط دستکش های پرسنل و دست های بازدیدکننده یا از طریق گرد و غبار که پس از رسوب بر روی سطوح ممکن است آلوده شود و سپس توسط سیستم های همرفت طبیعی یا هوای مطبوع مجدداً معلق شود به بیماران منتقل شود.
بستری شدن در اتاقی که بیمار قبلی در آن کلونیزه شده یا به استافیلوکوک اورئوس مقاوم به متی سیلین (MRSA)، انتروکوک مقاوم به وانکومایسین (VRE)، کلستریدیوم دیفیسیل، اسینتوباکتر مقاوم به چند دارو، کاندیدا کاندیدا کاندیدا یا مخمر مقاوم به چند دارو آلوده شده است. نشان دهنده یک عامل خطر اضافی برای بیمار بعدی که در اتاق بستری می شود.
مرتبط ترین پاتوژن های بیمارستانی که روی سطوح بی جان خشک باقی می مانند. باکتری های گرم منفی بیشتر از باکتری های گرم مثبت باقی می مانند. رطوبت ماندگاری چندین نوع باکتری (مانند کلامیدیا تراکوماتیس، لیستریا مونوسیتوژنز، سالمونلا تیفی موریوم، سودوموناس آئروژینوزا و اشریشیا کلی) را بهبود می بخشد، در حالی که تنها استافیلوکوکوس اورئوس در رطوبت کم ماندگاری بیشتری دارد.
مقالات بیشتر:
تست خون سازگاری و هولیز کنندگی
تشخیص اشرشیا کلی در محصولات پزشکی
پیشگیری از بروز آلودگی
هیچ استاندارد یا محدودیتی مبتنی بر سلامتی برای عوامل بیولوژیکی داخلی وجود ندارد.
تفاوت در فصل؛ شرایط آب و هوایی و هواشناسی؛ نوع، ساخت، سن و کاربری ساختمان و سیستم های تهویه. و تفاوت در پروتکل های اندازه گیری مورد استفاده در مطالعات مختلف (به عنوان مثال نمونه برداری از میکروارگانیسم زنده در مقابل غیرقابل زنده ماندن، نوع نمونه و تجزیه و تحلیل) تفسیر داده های نمونه برداری را نسبت به اطلاعات ادبیات پزشکی دشوار می کند.
این مشکلات در بیمارستانهایی تشدید میشوند که وضعیت سلامت بیمار، فعالیتهایی که صورت میگیرد و انتشار بالقوه عوامل بیولوژیکی بیماری زا، سطح پیچیدگی را نسبت به سایر محیطهای داخلی افزایش میدهد. علاوه بر این، بار جهانی عفونت مرتبط با مراقبت های بهداشتی به دلیل دشواری جمع آوری داده های تشخیصی قابل اعتماد ناشناخته است.
تعریف نقشی که محیط در کسب عفونت های بیمارستانی دارد با نیاز به استراتژی های متعدد برای کنترل انتشار میکروارگانیسم های بیماری زا و اتخاذ اقدامات پیشگیرانه برجسته می شود.
از آنجایی که روزانه نزدیک به 106 پوسته پوستی حاوی میکروارگانیسمهای زنده از پوست معمولی ریخته میشود، غیرمنتظره نیست که بیماران - از طریق روپوشها، ملحفههای تخت، مبلمان کنار تخت و سایر اشیاء نزدیک به آنها - به سایر فلورهای بیمار آلوده شوند.
روشن شدن نقش سطوح در گسترش عفونت ها می تواند حمایتی برای افزایش پایبندی به اقدامات کنترلی باشد. بهبود و تشدید روال تمیز کردن ممکن است انتشار عوامل بیماری زا را کاهش دهد.
هنگام تمیز کردن سطوح باید به کفایت طول، فرکانس و مراقبت ویژه بیشتر توجه شود، زیرا حذف کثیفی به کاهش بیوفیلم ها کمک می کند.
با استفاده از مهندسی و راهبردهای کنترل محیطی می توان از انتشار پاتوژن ها جلوگیری کرد. بنابراین، در اعتیاد به روش های استاندارد تمیز کردن و ضد عفونی کردن، نگهداری اهداف بهداشتی مناسب ممکن است با استفاده از مواد ضد میکروبی بادوام، مانند مس و آلیاژهای مس (برنج و برنز)، به ویژه برای سطوح با لمس بالا، به دست آید.
سطوح لمسی مس ضد میکروبی می تواند تعداد میکروب ها را بر روی سطوح کاهش دهد، خطر را کاهش داده و از انتقال مقاومت آنتی بیوتیکی بین گونه های باکتریایی جلوگیری می کند .
علت مسئله چندمقاومت بیوسید میکروبی، در سال های اخیر روش های جدید بهداشتی مبتنی بر استفاده از محصولات پروبیوتیک مورد بررسی قرار گرفته است.
این تکنیک که به عنوان تثبیت زیستی شناخته می شود بر اساس اصل حذف میکروبی رقابتی است و به یک عمل بیوسیدال دلالت نمی کند. سطوح ضدعفونی کننده محصولات پروبیوتیک حاوی اشکال رویشی و اسپور گونه های باسیلوس، در ارتباط با اقدامات بهداشتی خوب، به نظر می رسد باعث کاهش 80-90٪ عوامل بیماری زا و بیش از 60٪ کاهش حوادث عفونت می شود.
به منظور جلوگیری از عفونت های ناشی از میکروارگانیسم های موجود در هوا، حفظ موانع محافظتی که کیفیت میکروبیولوژیکی هوا را کنترل می کنند بسیار مهم است.
برای پاتوژن های معلق در آب، شیرها به راحتی برای اقدامات پیشگیرانه در دسترس هستند و به نظر می رسد نصب فیلترهای یکبار مصرف در خروجی های آب بیمارستانی یک مفهوم موثر برای کاهش انتقال پاتوژن های بیمارستانی از آب به بیمار باشد.
برنامه های کنترل عفونت توسط نیکوفارمد و مراکز کنترل بیماری تعریف شده است. بهبود سیستم های نظارتی برای عفونت های بیمارستانی و اجرای روش های استاندارد برای کاهش انتشار میکروبی تعهدات اصلی را نشان می دهد.
تجهیزات پزشکی یا سایر محصولات پزشکی، صرف نظر از اینکه چقدر برای تولیدشان ضروری است، اگر در محیط های استریل تولید شوند و پس از تولید تحت هر گونه فرآیند استریلیزاسیون قرار گیرند، می توانند حامل برخی از میکروارگانیسم ها باشند. مقدار بار بیولوژیکی روی محصول پس از تولید، اندازه و جمعیت میکروارگانیسم نامیده می شود.
برای تعیین میزان بار زیستی، از آزمایش برای تعیین میزان بار زیستی استفاده می شود. در نتیجه آزمایش بار بیولوژیکی، وسایل پزشکی باید توسط سیستم های بسته بندی به گونه ای بسته بندی شوند که سطح پاکیزگی تعیین شده توسط سیستم مدیریت تجهیزات پزشکی حفظ شود.
بزرگترین جنبه آزمایش مقدار میکروارگانیسم ها بر روی دستگاه های پزشکی و محصولات دارویی با به حداقل رساندن خطر سرایت میکروبیولوژیکی تعیین می شود. برای این منظور در ضمیمه 1: ماده مقررات تجهیزات پزشکی آمده است که «دستگاه های پزشکی استریل، سیستم های بسته بندی باید سطح تمیزی دستگاه پزشکی را بدون خراب شدن دستگاه پزشکی حفظ کنند و در صورتی که دستگاه پزشکی استریل شده باشد. قبل از استفاده، باید آلودگی میکروبیولوژیکی را به حداقل برساند
آزمایش بار زیستی چه زمانی انجام می شود؟
هنگامی که آزمایش بار زیستی انجام می شود، اعتبار استریلیزاسیون محصول سازنده دستگاه پزشکی یا محصول پزشکی یکی از اولین الزاماتی است که باید بدانید. از آنجایی که تعداد موجودات زنده روی محصولات مشخص است، عقیم سازی قبل از اعتبار کار انجام می شود.
در نتیجه آزمایش بار زیستی چه کاری انجام می شود؟
با توجه به نتایج آزمایش بار زیستی ، مشخص می شود که آیا محصول دارای استریلیزاسیون معتبر است یا خیر. اگر آزمودنی دارای عقیم سازی معتبر نباشد، این موضوع بر اساس نتایج آزمایش مشخص می شود. مطالعات عقیم سازی با در نظر گرفتن تعداد، اندازه و نوع موجودات زنده روی محصول تعیین می شود.
این روش ها عموماً روش های اختلاط دستی یا خودکار، گردابی، اختلاط، شستشو و سوابینگ می باشد. این روش در روش تمیز کردن تجویز شده اجرا می شود. پس از اعمال، محصول را می توان تحت آزمایش قرار داد.
بار زیستی نیز قبل از استریل شدن محصول استفاده می شود. میکروارگانیسم ها می توانند به اشکال مختلف قبل از استفاده از محصول وجود داشته باشند. این بهترین راه برای نگهداری محصولات این موجودات در محیط های استریل است.
قبل از استفاده، این بار زیستی ممکن است به سایر بیمارستان ها یا کارکنان مراقبت های بهداشتی در محیط های مراقبت های بهداشتی مانند اتاق های عمل سرایت کند. این امر خطر عفونت را در این محیط ها افزایش می دهد. بنابراین، بار زیستی یک محصول تنها پس از ورود به بازار باید در نظر گرفته شود.
تست حلال چیست؟ تست اندوتوکسین باکتریایی
اندوتوکسین را می توان به طور خلاصه به عنوان یک جزء ساختاری باکتری بیان کرد. به عبارت دیگر، اندوتوکسین، جزئی از غشای خارجی سلول های باکتریایی گرم منفی نیز با تعریف آن ظاهر می شود. اندوتوکسین زمانی تشکیل می شود که باکتری ها به دلایل مختلف ساختار استاندارد خود را از دست بدهند. به طور خلاصه، اشتباه نیست اگر بگوییم این ساختار همان ساختار باکتریایی تکه تکه شده است.
اگرچه در مورد اندوتوکسین با تعاریف زیادی مواجه می شویم، اما به سادگی می توان گفت که آخرین سنگر باکتری های گرم منفی قبل از مرگ است. آزمایش اندوتوکسین باکتریایی آزمایش حلال نیز نامیده می شود. به لطف آزمایش حلال، ساختار سمی باکتری های گرم منفی روی دیواره سلولی به سرعت و به راحتی آشکار می شود. این تست اخیراً محبوبیت بیشتری پیدا کرده است و در بسیاری از صنایع مورد استفاده قرار گرفته است. از آنجایی که مواد سمی روی محصولات با آزمایش حلال تشخیص داده می شود، تامین آن توسط تولیدکنندگان بسیار مهم است.
از آنجایی که نتایج آزمون حلال اغلب منعکس کننده حقیقت است، در زمینه های بسیار مهمی هم در کشور ما و هم در سراسر جهان استفاده می شود. شرکت های داروسازی اغلب به آزمایش حلال در مناطقی که نیاز به حساسیت و مراقبت شدید دارند، مانند دستگاه های پزشکی و آب دیالیز متوسل می شوند. به لطف تست حلال، مواد سمی روی این محصولات شناسایی شده و اقدامات لازم انجام می شود. امروزه تقریباً در تمام زمینه های پزشکی و تجهیزات پزشکی می توان با استفاده از تست حلال مواجه شد. شما می توانید از طریق تماس با ما از طریق شرکت ما اطلاعات دقیقی در مورد آزمون حلال و صحت نتایج بدست آورید.
تست حلال روی کدام محصولات انجام می شود؟
در واقع پاسخ های زیادی برای این سوال وجود دارد که تست حلال روی کدام محصولات استفاده می شود. اما در برخی مناطق استفاده از این تست بسیار رایج تر است. تست حلال به طور مداوم توسط شرکت های تولید کننده تجهیزات پزشکی استفاده می شود. این مواد شامل ضربان ساز، قلب و عروق، محصولاتی هستند که در تماس مستقیم با مایع مغزی نخاعی هستند. از آنجایی که این مواد برای زندگی افراد مبتلا به این بیماری بسیار مهم هستند، آزمایش باید با دقت انجام شود.
محیطی که تست حلال در آن انجام می شود باید استریل شود. این برنامه نیاز به توجه دارد زیرا بهداشت ممکن است بر نتیجه آزمایش تأثیر بگذارد. در عین حال، آگاهی و قابلیت اطمینان شرکت هایی که تجزیه و تحلیل می کنند بسیار مهم است. شرکت ما در زمینه آنالیز مواد پزشکی مانند تست حلال نامی برای خود دست و پا کرده و با تجربه خود در بازار جایگاهی را به دست آورده است. اگر می خواهید از خدمات ما بهره مند شوید که واضح ترین نتایج را ارائه می دهد و کیفیت آنها را تحت تاثیر قرار می دهد، می توانید با تیم متخصص ما تماس بگیرید.
شرکت ما نه تنها بر روی مواد پزشکی تجزیه و تحلیل می کند، بلکه با آزمایش هایی در زمینه هایی مانند غذا، آب و لوازم آرایشی و بهداشتی نامی برای خود دست و پا می کند. با محبوبیت بیشتر تست حلال در سال های اخیر و گسترش آن در بین شرکت های تولید کننده تجهیزات پزشکی، شرکت ما بیشتر به میدان آمده است. با تجزیه و تحلیل ما، می توانید از قابلیت اطمینان موادی که مستقیماً بر زندگی انسان تأثیر می گذارد مطمئن شوید. برای اطلاعات دقیقتر می توانید با ما تماس بگیرید.
مقالات بیشتر:
روند گزارش گیری آزمون حلال چگونه است؟
قبل از آزمایش حلال، یک محیط آزمایشگاهی استریل شده تهیه می شود و محصولات مورد آزمایش تعیین می شوند. پس از فراهم شدن شرایط مناسب، آزمایش به صورت کاملاً بهداشتی و حساس انجام می شود. پس از انجام آزمایش، یک دوره زمانی معین باید بگذرد تا بتوان گزارش دهی را انجام داد. پس از مدت زمان مشخص گزارش گیری مطابق با نتیجه آزمایش انجام می شود و شرکت های تولید کننده محصول بر اساس این نتیجه عمل می کنند.
ما به عنوان گروه متخصصین سال ها تجربه در زمینه های تجزیه و تحلیل و آزمایش داریم. با پیشرفت تکنولوژی هر روز روش ها و روش های کاربردی جدید را امتحان می کنیم. نرم افزار تست حلال ما، مانند سایر تست های ما، در محیط های آزمایشگاهی انجام می شود تا دقیق ترین نتایج را ارائه دهد. شرکت ما با توجه به کیفیت خدمات خود قیمت های بسیار مناسبی را ارائه می دهد. برای اطلاعات دقیق در مورد خدمات، قیمت ها و تجزیه و تحلیل ما می توانید با ما تماس بگیرید. در عین حال می توانید خدمات ما را در وب سایت ما بررسی کنید.
با توجه به همه گیری کووید، اصطلاح بار میکروبی یا ویروسی در بین شهروندان رایج شده است. با این مفهوم مهم زیستی، در نظر گرفته شده است که به طور مکرر مسری بودن، شدت، پیش آگهی و غیره توضیح داده شود. بررسی اهمیت جمعیت و کاربردهای پزشکی آن مناسب به نظر می رسد.
تعریف
بار در یکی از معانی متعدد «چیزی است که بر دیگری سنگینی می کند». در تمام زمینه های دانش به معنای جایگزینی (باتری)، مواد منفجره، مالیات (مالی)، هزینه ها (خانواده) و غیره استفاده می شود. در حوزه اجتماعی، بار هزینه یا مراقبت یک فرد یا گروه است که باید بر عهده گروه دیگری باشد.
در اکولوژی، ملاقات دو یا چند گونه یک تعامل بیولوژیکی ایجاد می کند که وقتی حفظ شود، یک رابطه بین گونه ای ایجاد می کند (مثلا Microbiota). این مصداق کامنسالیسم، متقابل گرایی، همزیستی، انگلی و غیره است. بار جزء مهمی از انگلی است که در پویایی جمعیت، چه بین انسان، چه حیوانات بالاتر و چه موجودات تک سلولی و ویروس ها، اساسی است.
مفهوم بار در پزشکی
به عنوان مثال، در حوزه سلامت، بار مراقبتی به حجم فعالیت مراقبتی یک واحد، خدمات یا بیمارستان اشاره دارد که با شاخص های مختلف می توان آن را کمی کرد. بار بیماری، بار یک بیماری خاص را به هزینه درمان آن بیماری مرتبط می کند.
نقش روشنی در روابط بین ارگانیسم های سطوح مختلف سازمان مانند انسان - پاتوژن های میکروبی به دست می آورد. در یک رابطه انگلی، پاتوژن ها زنده می مانند و به قیمت میزبان تکثیر می شوند. آنها باری بر بدن هستند. این مفهوم از آنجایی اهمیت علمی پیدا می کند که امکان کمی سازی آن وجود داشته است. به عنوان مثال، در Health، بار (کمی) باکتری های کلیفرم در آب آشامیدنی یا غذا نشانگر آلودگی مدفوع است. در حال حاضر، تکامل بار ویروسی کووید-19 در فاضلاب برای دنبال کردن روند شیوع یا امواج همهگیری قابل تخمین است.
در پاتولوژی، نقشه راهی که پاتوژن ها از آن پیروی می کنند تا زمانی که علائم بالینی ایجاد کنند را می توان در 3 مرحله ترسیم کرد: کلونیزاسیون، عفونت و بیماری. در هر سه مورد، بار میکروبی مهم است. در مرحله اول، پاتوژن باید با میکروبیوتای پوست و مخاط رقابت کند و باید با تعداد کمی از گیرنده های سلولی موجود سازگار شود. تنها در صورتی که بسیار بیماری زا باشد یا بار برای جایگزینی میکروبیوتا کافی باشد، به مرحله 2 می رود.
مرحله عفونی در مواجهه با مقاومت غیر اختصاصی (پوست، ترشحات، سرفه و غیره)، پاتوژن ها با بار کم از خود دفاع می کنند، در بیوفیلم ها ادغام می شوند، جهش می یابند و غیره. پیامد این پویایی معمولاً پیروزی میزبان است. استثنائاتی مانند تغییر اولین سد دفاعی، سمیت مستقیم پاتوژن یا تلقیح مستقیم وجود دارد. در بیماری های همراه، عبور مستقیم برخی از ویروس ها به ریه، ضربه، تلقیح توسط ناقلان بندپایان و غیره دیده می شود. سپس پاتوژن مزیت ظاهری دارد، زیرا نیازی به بیماری زایی خاص یا بار میکروبی زیاد ندارد. اما دفاع هومورال غیر اختصاصی (لکوسیت ها، مکمل) و اختصاصی (آنتی بادی ها و لنفوسیت ها) برای موفقیت میزبان کافی است.
اگر اینطور نبود، ما به مرحله 3 می رویم که تظاهرات بالینی بر آن نظارت می شود. آنها به دلیل افزایش بار میکروبی، با سمیت پاتوژن، واکنش دفاعی میزبان (التهاب، فیبروز، حساسیت بیش از حد و غیره) یا هر دو هستند. به همین دلیل است که پذیرفته شده است که کلونیزاسیون توسط یک پاتوژن نادر است، عفونت نادر است، و بیماری استثنایی است.

اهمیت بالینی بار باکتریایی
رشد باکتری ها نمایی است، خوشبختانه فقط در تئوری. یک سلول باکتریایی با زمان تولید 18 تا 20 دقیقه، در عرض 5 تا 8 روز، جرم جمعیتی بزرگتر از زمین ایجاد می کند. این بار نظری توسط مواد مغذی، اسیدی شدن متابولیک، تضاد با میکروبیوتای از پیش موجود و جهشهای مکرر ناسازگار با زندگی به خطر میافتد.
هر پاتوژنی نیاز به سازگاری دارد و تنها زمانی تکثیر می شود که شرایط مساعد باشد. اما آنها این کار را "بی سر و صدا" انجام خواهند داد تا خصومت محیط را تحریک نکنند. هنگامی که یک گروه باکتریایی شرایط خوبی را درک می کند، سیگنال «کوروم» (حس نصاب) را می دهد که با بقیه جمعیت ارتباط برقرار می کند تا پرخاشگری را آغاز کنند. آنها باعث افزایش تکثیر، ترشح آنزیم ها، سموم، تشکیل بیوفیلم،... در میان سیگنال های «نصاب»، پروتئین های مشابهی در همه گونه های مورد مطالعه شناسایی شده است. بیان این "هوش" میکروبی حداقل بار و تکامل آن در دینامیک عفونی است.
مطالعات "نصاب" با سودوموناس و حداقل بار با مزارع ماهی قزل آلا، لازم برای تولید عفونت های سمی، و با استافیلوکوک ها در عفونت های جراحی کلاسیک است. اما این عفونت های ادراری است که نقش بار باکتریایی بیشتر شناخته شده است. شمارش باکتری های ادرار (1000000 تا 1000000 واحد تشکیل کلنی در میلی لیتر) برای تشخیص، اثربخشی درمانی و نتیجه معمول است.
اهمیت بالینی بار ویروسی
در ایدز به خوبی شناخته شده است، بار شامل مقدار ویروس (HIV) موجود در خون یا مایعات دیگر است. با تعداد نسخه های ویروس در هر میلی لیتر اندازه گیری می شود. بین بار غیرقابل تشخیص (زیر 50 نسخه) و بار زیاد (صد هزار تا یک میلیون نسخه) در نوسان است. اگرچه فاز تکثیر داخل سلولی را تشخیص نمی دهد، اما به معنای پیشرفت بزرگی در ارزیابی مسری بودن، تشخیص، پیش آگهی و اثربخشی درمانی است.
در COVID-19، با تکثیر سریع، بار در CT یا حداقل تعداد چرخه (PCR) لازم برای رسیدن به سطوح قابل تشخیص ویروس اندازهگیری میشود. هرچه تعداد TC کمتر باشد، بار ویروسی بیشتر است و بالعکس. بالاتر یا کمتر از یک عدد معین (-) یا (+) در نظر گرفته می شود که راه اطلاع رسانی به بیمار است.
در مطالعات اولیه، بارهای بسیار بالا (10 میلیارد نسخه) نشان دهنده کاهش دوره کمون، مسری بودن بیشتر و احتمالاً شدت بیشتر است. (Marks, M. et al: The Lancet, May 2021).
در کووید، برخلاف ایدز، بار ویروسی بیش از همه در اسمیر و ترشحات تنفسی مورد مطالعه قرار می گیرد. در حال حاضر بارهای شاخص فاز بالینی، پاتوژنز ریوی، پیش آگهی، اثربخشی درمانی و واکسن و ... در حال بررسی است که بسیار مفید خواهد بود.
آزمون تعیین بار میکروبی|پایش میکروبی|پلیت های آماده میکروبی|تست میکروبی





